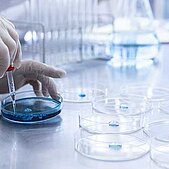
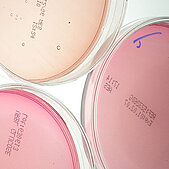
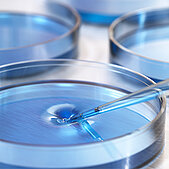

Industries




Personal Care
High-quality raw materials and active ingredients for the Personal and Home Care industries.

Home Care and I&I
We specialise in raw materials for washing detergent and cleaning products and provide green, efficient solutions.

Performance Chemicals
Raw materials and additives that optimize processes and products both functionally and financially.
Industries




Personal Care
High-quality raw materials and active ingredients for the Personal and Home Care industries.

Home Care and I&I
We specialise in raw materials for washing detergent and cleaning products and provide green, efficient solutions.

Performance Chemicals
Raw materials and additives that optimize processes and products both functionally and financially.










![[Translate to English:] Pharma Produktkatalog Deutschland [Translate to English:] Pharma Produktkatalog Deutschland](/fileadmin/_processed_/7/2/csm_Catalogue_Pharma_DE_929a477b7d.png)


![[Translate to English:] [Translate to English:] Gnosis](/fileadmin/user_upload/ES/Pictures/Nutraceuticals/Proveedores/Supplier_Gnosis.jpg)












![[Translate to English:] NEOCARE P3R [Translate to English:] Ce produit est un émulsionnant végétal E/H](/fileadmin/_processed_/4/9/csm_Shadow_Ingredient_Neocare_P3R-1_79da566508.jpg)







![[Translate to English:] Maquillage visible [Translate to English:] Voici un concept de notre partenaire Cobiosa](/fileadmin/_processed_/0/6/csm_Cobiosa_-_Maquillage_Visible_442137c963.jpg)

![[Translate to English:] [Translate to English:]](/fileadmin/_processed_/1/c/csm_news-header-mkare_04_9d268e242d.jpg)
![[Translate to English:] [Translate to English:]](/fileadmin/_processed_/0/f/csm_2024_DE_Green_alternatives_726x385ppix_DE_b497958a40.png)

![[Translate to English:] [Translate to English:]](/fileadmin/_processed_/2/a/csm_2507_CH_Proteins_Flyer_31471a2182.png)




![[Translate to English:] KitoZyme [Translate to English:] KitoZyme](/fileadmin/user_upload/ES/Pictures/Nutraceuticals/Proveedores/Supplier_Kitozyme.jpg)


![[Translate to English:] COSMET’AGORA 2023 [Translate to English:] IMPAG vous accueillira: COSMET’AGORA 2023](/fileadmin/user_upload/FR/Pictures/Events/Cosmetagora2023_annonce.jpg)







![[Translate to English:] Jade Roll [Translate to English:] Des matières premières pour les soins cosmétiques réduire les poches](/fileadmin/_processed_/9/9/csm_Cobiosa-Jade-Roll_95ebb2a21a.jpg)



![[Translate to English:] [Translate to English:]](/fileadmin/user_upload/CH/Pictures/Food/Logos/Shankar_web.jpg)







![[Translate to English:] Soin des sourcils [Translate to English:] IMPAG offre des matières premières pour le soin des sourcils](/fileadmin/_processed_/7/3/csm_Cobiosa-Eyebrows-Care_479634b373.jpg)








![[Translate to English:] [Translate to English:]](/fileadmin/_processed_/7/4/csm_2024_04_in-cosmetics_1c5a802126.png)


















![[Translate to English:] EMSLAND GROUP [Translate to English:] EMSLAND GROUP](/fileadmin/_processed_/e/8/csm_Emsland_Logo_67f1f6ffdb.jpg)










![[Translate to English:] Kroener Staerke, Alemania [Translate to English:] Kroener Staerke, Alemania](/fileadmin/user_upload/ES/Pictures/Nutrition_and_Health/Proveedores/Supplier_KRONER_.jpg)





![[Translate to English:] Fecc Mitgliedschaft](/fileadmin/_processed_/0/d/csm_impag-news-fecc-membership_f158bf44ce.png)
![[Translate to English:]](/fileadmin/user_upload/CH/Pictures/Pharma/Logos/klk-oleo-emmerich-logo.png)

![[Translate to English:] Konservierungsmittel in Pharmaqualität [Translate to English:] Konservierungsmittel in Pharmaqualität](/fileadmin/_processed_/2/5/csm_Konservierungsmittel_iStock_1182619006_726x385_ea7eca0037.jpg)


![[Translate to English:] Mascné [Translate to English:] NULL](/fileadmin/_processed_/9/9/csm_Cobiosa_Maskne_4ba2416795.jpg)







![[Translate to English:] Glukonian Chlorheksydyny 20% [Translate to English:] Glukonian Chlorheksydyny 20%](/fileadmin/_processed_/3/8/csm_Chlorhexidine_iStock-526214185_9ffda2d5f9.jpg)
![[Translate to English:] [Translate to English:]](/fileadmin/_processed_/d/e/csm_2022-11-17-73108_Award_726_2b20cd3bb5.jpg)

![[Translate to English:] Topische galenische Formen [Translate to English:] Topische galenische Formen](/fileadmin/_processed_/a/7/csm_Topical_galenic_forms_Fotolia_102116769_XXL_726x385_10dbcc71f4.jpg)
![[Translate to English:] sole chlorheksydyny [Translate to English:] Sole chlorheksydyny](/fileadmin/user_upload/FR/Pictures/Personal_Care/Fokusberichte/Chlorhexidin_Focus_v.jpg)
![[Translate to English:] [Translate to English:]](/fileadmin/_processed_/5/3/csm_2023_Oil_Inclusive_89d7a7ba79.jpg)









![[Translate to English:] Concept Haircare [Translate to English:] Des ingrédients pour les soins capillaires](/fileadmin/_processed_/3/a/csm_Concept_Haircare_cobiosa_3b7354fb89.jpg)



![[Translate to English:] Alternative végétale [Translate to English:] Ce produit est une alternative d'origine végétale au collagène d'origine animal](/fileadmin/_processed_/6/0/csm_TriK-Concept_9d8b449382.jpg)

![[Translate to English:] Superfood [Translate to English:] Le concept superfood pour l'industrie cosmétique](/fileadmin/_processed_/f/b/csm_Cobiosa-Superfood_concept_b9c9a22efb.jpg)
![[Translate to English:] Nueva represenada: Arandovo [Translate to English:] Nueva represenada: Arandovo](/fileadmin/_processed_/a/1/csm_arandovo-nuevo-represenada_4c97d795c1.jpg)
![[Translate to English:] Cobiolift [Translate to English:] Ce sont des polysaccharides issus du quinoa](/fileadmin/_processed_/c/0/csm_Cobiosa-COBIOLIFT_concept_170baf9c32.jpg)

![[Translate to English:] Vegetable Collagen, Vegetable Keratin, HEMP TEIN Z NPNF [Translate to English:] NULL](/fileadmin/_processed_/1/e/csm_Vegetable_Collagen_Vegetable_Keratin_HEMP_TEIN_Z_NPNF_b4b84e51e4.jpg)
![[Translate to English:] COBIOCARE [Translate to English:] NULL](/fileadmin/_processed_/3/e/csm_cobiocare_bf4263c380.jpg)
![[Translate to English:] Rohmaterialien in Pharmaqualität [Translate to English:] Rohmaterialien in Pharmaqualität](/fileadmin/_processed_/2/f/csm_Stearinsaeuren_Fotolia_94508475_XXL_726x385_23de391d8c.jpg)







![[Translate to English:] Home office skin care protection [Translate to English:] Protection de la peau au bureau à domicile](/fileadmin/_processed_/7/8/csm_Concept_Cobiodefender_ff467df9fb.jpg)
![[Translate to English:] Cosmetic fitness work out [Translate to English:] Entraînement esthétique](/fileadmin/_processed_/a/9/csm_Concept_Calling42_0a4ff6008c.jpg)












![[Translate to English:] [Translate to English:]](/fileadmin/_processed_/4/7/csm_News-Header-industrial-science-linkedin_52c791c4f8.jpg)

![[Translate to English:] Cobiosa [Translate to English:] Cobiosa](/fileadmin/user_upload/FR/Pictures/Personal_Care/Logos/Cobiosa_2022-web.png)





![[Translate to English:] Beauty Reloaded: Inspiring Formulas for Demanding Times](/fileadmin/_processed_/7/d/csm_beauty-reloaded_NEWS_092c00cbc7.jpg)
![[Translate to English:] Finding the Beauty in Beauty [Translate to English:] NULL](/fileadmin/_processed_/5/2/csm_Concept_Skin-Care-Trends_95d1d22320.jpg)

![[Translate to English:] Believe in your skin [Translate to English:] Croyez en votre peau](/fileadmin/_processed_/9/4/csm_Concept_BelieveInYourSkin_daa2a30c07.jpg)

![[Translate to English:] Hands care [Translate to English:] Soins des mains](/fileadmin/_processed_/1/a/csm_Concept_Calling40_HandsCare_e9420db356.jpg)



![[Translate to English:] Kitozyme [Translate to English:] Kitozyme](/fileadmin/user_upload/ES/Pictures/Pharma/Proveedores/Supplier_KitoZyme.jpg)

![[Translate to English:] Diamenty Forbesa 2022 [Translate to English:] Diamenty Forbesa 2022](/fileadmin/_processed_/6/c/csm_Forbes_2022_352_e94363520e.jpg)







![[Translate to English:] [Translate to English:]](/fileadmin/_processed_/4/0/csm_Jornadas_Novedades_May26_726x385ppix_2d5e5521aa.jpg)
![[Translate to English:] Cosmetorium 2022 [Translate to English:] Cosmetorium 2022](/fileadmin/_processed_/c/a/csm_ES_Ankuendigung_Cosmetorium_726x385ppix_d21d5a9fcd.jpg)
![[Translate to English:] [Translate to English:]](/fileadmin/_processed_/f/1/csm_Bilder_Website_726x385ppix_eaab0141c9.jpg)














![[Translate to English:] Coating Products Logo](/fileadmin/user_upload/CH/Pictures/Performance_Chemicals/Logos/coating-products-logo.png)






![[Translate to English:] 2-EHMA [Translate to English:] 2-EHMA](/fileadmin/_processed_/1/3/csm_Flyer_EHMA_Bild_f5d545fbf2.jpg)

![[Translate to English:] [Translate to English:]](/fileadmin/_processed_/6/4/csm_news-header-mkare_03_631d9ee89c.jpg)










![beautycare 29 [Translate to English:] Nos dernières nouevautés !](/fileadmin/_processed_/c/8/csm_beautycare29_4910d3c8a5.jpg)













![[Translate to English:] [Translate to English:]](/fileadmin/_processed_/8/1/csm_ES_Phytopin_726x385ppix_b37f3bc727.jpg)











![[Translate to English:] [Translate to English:] IMPAG AG Logo](/fileadmin/user_upload/CH/Pictures/Performance_Chemicals/Logos/impag-ag-logo.png)




![[Translate to English:] [Translate to English:]](/fileadmin/_processed_/a/2/csm_ES_Alpha-Bisabolol_726x385ppix_490f813d45.jpg)
![[Translate to English:] [Translate to English:]](/fileadmin/_processed_/3/2/csm_ES_Aloe-Vera_726x385ppix_c0547047b2.jpg)






![[Translate to English:] Neuroserine [Translate to English:] Neuroserine](/fileadmin/_processed_/e/5/csm_Neuroserine_298540944_726x385_97bb15d03b.jpg)












![[Translate to English:] AAEM - Flyer [Translate to English:] Aktualisierter Flyer über AAEM](/fileadmin/_processed_/3/5/csm_shutterstock_1227605062_AAEM_news_726_8dc7b1abdb.jpg)



























![[Translate to English:] Mutsuya Boeki](/fileadmin/user_upload/CH/Pictures/Water/Logos/csm_mutsuya-boeki.png)

![[Translate to English:] Kenrich Petrochemicals, USA [Translate to English:] Kenrich Petrochemicals, USA](/fileadmin/user_upload/CH/Pictures/Performance_Chemicals/Logos/Kenrich_WEB.jpg)

![[Translate to English:] Perlastan C-30 [Translate to English:] Perlastan C-30](/fileadmin/_processed_/8/4/csm_Perlastan_C30_Fotolia_200100562_XXL_bearb_e16f970165.jpg)


![NULL [Translate to English:] Découvrez nos dernières nouveautés !](/fileadmin/_processed_/d/4/csm_Beautycare_10_2017_WEB_c4f957d568.jpg)







![[Translate to English:] Supply Chain Update im Kontext des Coronavirus (Covid-19) [Translate to English:] NULL](/fileadmin/_processed_/c/b/csm_Update_Pandemic_Influenza_Coronavirus_2020_03_20_24280203d9.jpg)

![[Translate to English:] Miwon [Translate to English:] Miwon](/fileadmin/_processed_/9/c/csm_MIWON_726x385ppix_600e4901df.jpg)










![[Translate to English:] PREBIULIN ORAL [Translate to English:] PREBIULIN ORAL : prébiotique naturel pour les soins bucco-dentaires !](/fileadmin/_processed_/3/3/csm_Prebiulin_Oral_726-385ppix_e0826e96a5.jpg)






![[Translate to English:] Certification ISO14001 [Translate to English:] Certification ISO14001](/fileadmin/_processed_/2/a/csm_ISO14001_mailingbild_PL_FR_69d5534099.jpg)

















![[Translate to English:] LaBiotre](/fileadmin/user_upload/ALL/used_by_all/labiotre-logo_169x169px.png)















![[Translate to English:] Base de données produits [Translate to English:] Un service pour les clients d'IMPAG France qui facilite l'accès au documents](/fileadmin/_processed_/c/8/csm_myimpag_iStock-915186380_a8fce2b76d.jpg)

![[Translate to English:] MFCI](/fileadmin/_processed_/c/3/csm_MFCI_Logo_352_01_c2fac6be60.jpg)



















![[Translate to English:] Upgrain Logo](/fileadmin/user_upload/CH/Pictures/Food/Logos/upgrain-logo.png)











![[Translate to English:] NULL [Translate to English:] NULL](/fileadmin/_processed_/c/1/csm_64734527_fotolia_52fa6977bc.jpg)

























![[Translate to English:] Biozide von Lanxess [Translate to English:] Lanxess Biozide erhältlich bei IMPAG](/fileadmin/_processed_/3/8/csm_Fotolia_63445449_L_d198fc1a4e.jpg)



![[Translate to English:] Resin Kleen [Translate to English:] Resin Kleen erhältlich bei IMPAG](/fileadmin/_processed_/6/d/csm_Fotolia_63004859_L_052675d012.jpg)












![[Translate to English:] Münzig](/fileadmin/user_upload/CH/Pictures/Food/Logos/muenzig-logo.png)

































![[Translate to English:] Solina](/fileadmin/user_upload/CH/Pictures/Food/Logos/solina-logo.png)
![[Translate to English:] Stéarinerie Dubois](/fileadmin/user_upload/CH/Pictures/Food/Logos/stearinerie-dubois-logo.png)




![[Translate to English:] The Mediterranean Food Lab (MFL)](/fileadmin/user_upload/CH/Pictures/Food/Logos/the-mediterranean-food-lab-logo.png)